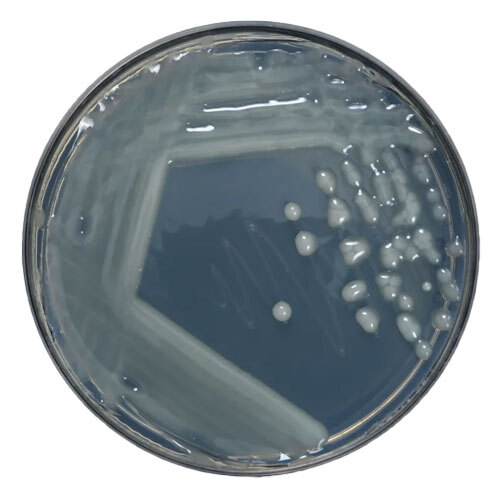
Azotobacter Bacteria - Ash %: A 1%

Azotobacter Chroococcum
Price:
Get Latest Price
In Stock
Product Specifications
| Features | Nitrogen fixation, Plant growth, Stress tolerance, Soil health |
| Main Export Market(s) | Asia, Australia, Central America, North America, South America, Eastern Europe, Western Europe, Middle East, Africa |
| Main Domestic Market | All India |
Company Details
Business Type
Exporter, Importer, Manufacturer, Supplier, Trading Company
Employee Count
50
Establishment
2000
Working Days
Monday To Sunday
GST NO
24AAJFP5389G1ZW
Related Products
Explore Related Categories
More Product From This seller
Seller Details
GST - 24AAJFP5389G1ZW
Ankleshwar, Gujarat
Partner
Mr Neil J Shah
Members since
15 Years
Address
Plot No. 906/13, Nr. Ganesh Anand Chokdi, GIDC Panoli, Dist. Bharuch, Ankleshwar, Gujarat, 394116, India
azotobacter in Ankleshwar
Report incorrect details